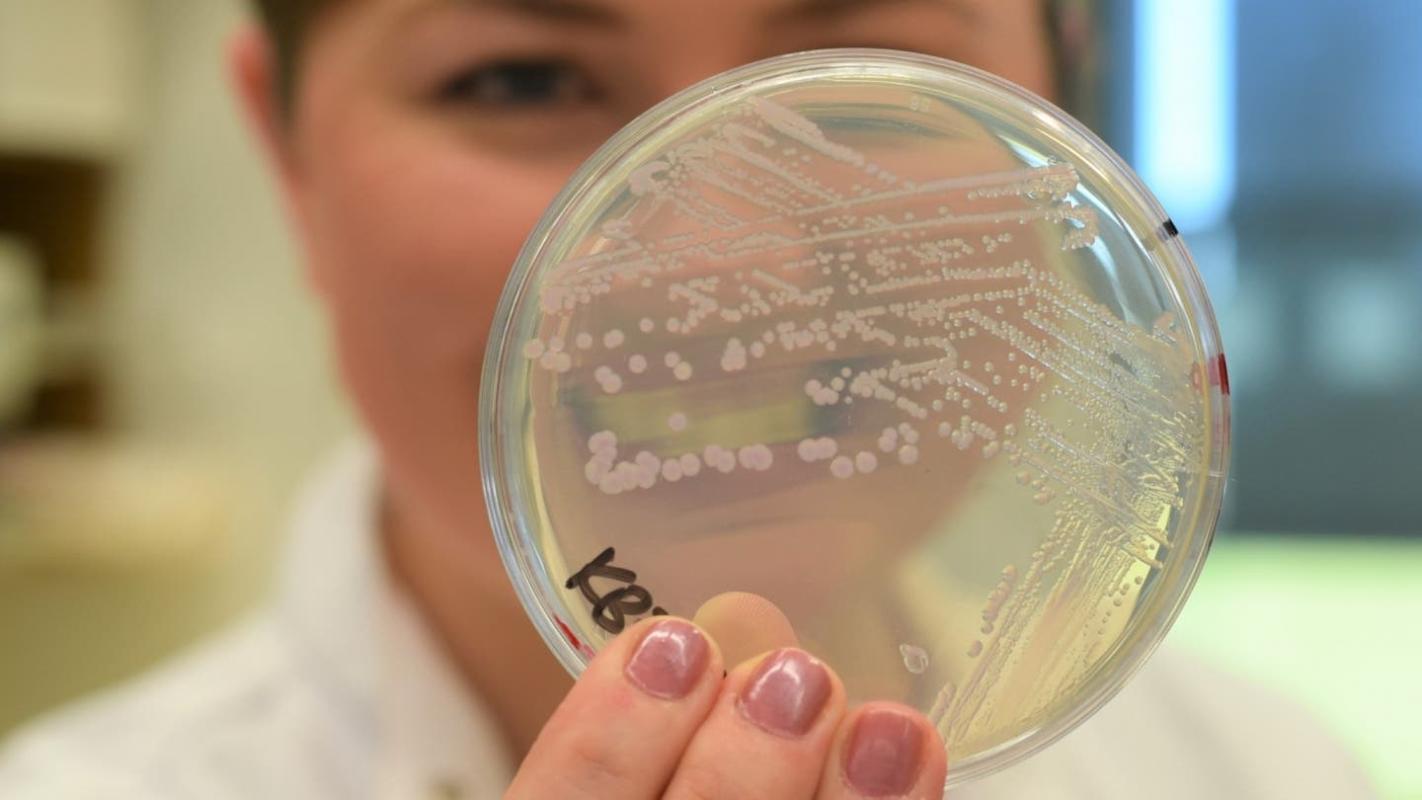

Las bacterias que se deshacen de su pared celular para evadir a los antibióticos
Las bacterias que se deshacen de su pared celular para evadir a los antibióticos
Las bacterias que se deshacen de su pared celular para evadir a los antibióticos
T13 En Vivo
Existen unas bacterias que son capaces de "hacer striptease" para evadir un ataque de antibióticos en el cuerpo humano.
Unos científicos de la Universidad de Newcastle, Reino Unido, identificaron a unas bacterias capaces de "desnudarse" para evitar que los medicamentos las detectaran, y sobrevivir.
Los investigadores filmaron a los microorganismos deshaciéndose de su capa externa o pared celular.
Los antibióticos suelen atacar las paredes celulares, por lo que los autores del estudio, publicado este miércoles en la revista especializada Nature Communications, creen que esta es una nueva forma de resistencia a los medicamentos.
Según ellos, este mecanismo también podría explicar por qué algunas infecciones resultan recurrentes.
Pero los expertos reconocieron que aún no estaba claro si este tipo de resistencia tiene algún impacto en los pacientes.
¿Qué es lo que se quitan las bacterias?
Algunas especies de bacterias tienen una pared celular formada por azúcares y aminoácidos (los componentes básicos de las proteínas) que les da forma y las protege.
"Imagínate que la pared celular es como que la bacteria lleva una chaqueta altamente visible", dijo la doctora Katarzyna Mickiewicz, investigadora de la Universidad de Newcastle y autora principal del estudio, a la BBC.
Pero al ser muy visible, la "chaqueta" es un punto débil, pues llama la atención del sistema inmunológico humano y de antibióticos como la penicilina, el primer antibiótico que se descubrió.
Este fármaco altera la pared celular y hace que las bacterias revienten.
El estudio de la Universidad de Newcastle analizó bacterias -como E. coli, Enterococo, Enterobacter y Estafilococo-, de 30 pacientes de edad avanzada con infecciones recurrentes en el tracto urinario.
Los investigadores descubrieron que algunas bacterias respondían a los antibióticos deslizándose fuera de su pared celular para evadir los efectos de los medicamentos.
"Arrojan la 'chaqueta' y la esconden dentro de ellas [...]. De esta manera, el cuerpo no puede reconocerlas fácilmente, por lo que no las ataca, y tampoco los antibióticos", explicó Mickiewicz.
Los científicos observaron también que la pared celular se regenera una vez que el antibiótico ha desaparecido.
¿Este mecanismo las mantiene vivas?
Los reportes de microbios sin pared celular no son nuevos: se llaman bacterias en forma de L.
Pero los estudiosos dicen que esta es la primera vez que demuestran que estos microorganismos pueden usar el truco para sobrevivir al tratamiento con antibióticos.
"Es absolutamente fascinante, estamos viendo algo diferente", dijo Mickiewicz.
"No todas sobreviven, solo unas pocas, pero pueden ser suficientes para causar una infección recurrente", agregó.
En el siguiente video, puedes ver el momento en que las bacterias se despojan de su pared celular y pierden su estructura original (como una barra), volviéndose más grandes y más débiles.
El sistema inmunológico del cuerpo debería ser capaz de eliminar a las bacterias en forma de L, pero podría fallar en pacientes de edad avanzada o con las defensas debilitadas.
¿Qué tan grave es el problema?
Las bacterias tienen muchos trucos bajo la manga para sobrevivir, como extraer el antibiótico de sus células o descomponer el químico u ocultar el orgánulo atacado por el medicamento.
La mayoría de estos mecanismos requieren una mutación en el código genético de la bacteria, que luego puede compartir con sus vecinas o transmitir a sus descendientes.
Sin embargo, el equipo de la Universidad de Newcastle dice que la separación de la pared celular parece no requerir una mutación genética.
"En ese sentido, es más preocupante que no necesiten cambiar nada, que no necesiten evolucionar y probablemente lo hagan mucho más seguido de lo que pensamos", detalló la doctora Mickiewicz a la BBC.
"Creo que esto es potencialmente relevante para prácticamente todas las infecciones bacterianas recurrentes", añadió.
¿Podría esto conducir a nuevos tratamientos?
Mickiewicz dice que la siguiente etapa es determinar qué bacterias tienen esta respuesta y qué papel juega el "truco" dentro de los pacientes.
Además, cree que la investigación puede conducir a nuevas ideas de tratamientos.
Puede ser posible superar esta resistencia con combinaciones de medicamentos que atacan tanto la pared celular como el funcionamiento interno de una bacteria, explica.
Sin embargo, para la profesora Laura Piddock, de la Universidad de Birmingham y directora de asuntos científicos de la organización Global Antibiotic R&D Partnership, "la relevancia clínica de esta historia no está clara", según dijo a la BBC.
"No veo esto como un mecanismo de resistencia a los antimicrobianos", sostuvo.
"Esta es una respuesta a la exposición a un antibiótico que permite que la bacteria sobreviva en presencia del medicamento", añadió.
Piddock señaló también que los antibióticos de primera elección recomendados para las infecciones del tracto urinario no atacan la pared celular.









